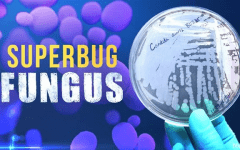

Candida auris
Nevada Sees Stabilization in Dangerous Fungal Infections After Spring Spike
By TheNevadaGlobeStaff, August 28, 2025 9:37 am
Infections caused by Candida auris, a fungus classified by the Centers for Disease Control and Prevention (CDC) as a multidrug-resistant “superbug,” have steadied in Nevada following a spike earlier this year, according to state health officials.
Data from the Nevada Division of Public and Behavioral Health (NDPBH) shows 189 cases reported in June, the most recent month with complete reporting. Of those, 47 were clinical infections and 138 were colonization cases, meaning the fungus was detected on a patient’s skin without causing illness.
Candida auris spreads through touch and can survive on surfaces, creating challenges in health care environments. Nevada began tracking cases in 2021, and since then has identified 6,539 cases, including 2,122 infections. Clinical cases peaked in March with 68, marking the seventh time in less than two years that infections surpassed 60 in a single month.
Sunrise Hospital and Medical Center in Las Vegas has reported the highest share of cases. A spokesperson said patients with open wounds face the greatest risk. However, state officials stopped publishing facility-specific case breakdowns in late 2024. They also no longer provide death data linked to C. auris, citing difficulty in determining whether the fungus was the primary cause given most patients’ other medical conditions.
Nationally, Nevada has ranked among the top five states for clinical cases, though its share of total U.S. infections has decreased as cases increase in larger states such as New York, California, Illinois, and Florida. From 2022 to 2023, Nevada accounted for roughly 14 percent of reported cases nationwide, a figure that dropped to 9 percent by the end of 2023.
Although reporting practices have shifted, the state continues to release weekly summaries that distinguish between clinical and colonization cases. Health officials emphasize that both types of data are important for understanding and containing the spread of the fungus.
Experts say strict cleaning and disinfection protocols remain the most effective defense against C. auris. The CDC estimates that 20 to 40 percent of patients with severe infections may not survive, underscoring the need for vigilance in hospitals and other care facilities.
Original source: 8 News Now / Nevada Division of Public and Behavioral Health
Copyright 2025 702 Times, NV Globe. All rights reserved.